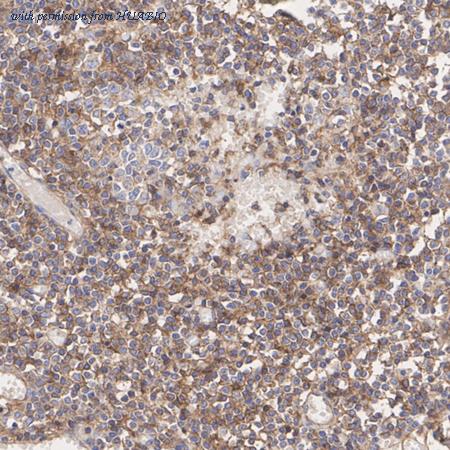
HUABIO HA751443 image 2

product summary
Loading...
company name :
HUABIO
product type :
antibody
product name :
beta 2 Microglobulin
catalog :
HA751443
quantity :
100μl
price :
649.00 USD
clonality :
monoclonal
host :
domestic rabbit
conjugate :
nonconjugated
clone name :
PSH12-14
reactivity :
human
application :
western blot, immunoprecipitation, flow cytometry, immunohistochemistry - paraffin section
more info or order :
image
image 1 :

Western blot analysis of beta 2 Microglobulin on different lysates with Rabbit anti-beta 2 Microglobulin antibody (HA751443) at 1/2,000 dilution.
Lane 1: HeLa cell lysate (20 µg/Lane)
Lane 2: Raji cell lysate (20 µg/Lane)
Lane 3: SH-SY5Y cell lysate (negative) (20 µg/Lane)
Lane 4: U-937 cell lysate (20 µg/Lane)
Predicted band size: 14 kDa
Observed band size: 12 kDa
Exposure time: 3 minutes; ECL: K1801;
4-20% SDS-PAGE gel.
Proteins were transferred to a PVDF membrane and blocked with 5% NFDM/TBST for 1 hour at room temperature. The primary antibody (HA751443) at 1/2,000 dilution was used in primary antibody dilution (K1803) at 4℃ overnight. Goat Anti-Rabbit IgG - HRP Secondary Antibody (HA1001) at 1/50,000 dilution was used for 1 hour at room temperature.
image 2 :
Immunohistochemical analysis of paraffin-embedded human lymph node tissue with Rabbit anti-beta 2 Microglobulin antibody (HA751443) at 1/1,000 dilution.
The section was pre-treated using heat mediated antigen retrieval with Tris-EDTA buffer (pH 9.0) for 20 minutes. The tissues were blocked in 1% BSA for 20 minutes at room temperature, washed with ddH2O and PBS, and then probed with the primary antibody (HA751443) at 1/1,000 dilution for 1 hour at room temperature. The detection was performed using an HRP conjugated compact polymer system. DAB was used as the chromogen. Tissues were counterstained with hematoxylin and mounted with DPX.
image 3 :

Immunohistochemical analysis of paraffin-embedded human kidney tissue with Rabbit anti-beta 2 Microglobulin antibody (HA751443) at 1/1,000 dilution.
The section was pre-treated using heat mediated antigen retrieval with Tris-EDTA buffer (pH 9.0) for 20 minutes. The tissues were blocked in 1% BSA for 20 minutes at room temperature, washed with ddH2O and PBS, and then probed with the primary antibody (HA751443) at 1/1,000 dilution for 1 hour at room temperature. The detection was performed using an HRP conjugated compact polymer system. DAB was used as the chromogen. Tissues were counterstained with hematoxylin and mounted with DPX.
product information
SKU :
HA751443
Target name :
beta 2 Microglobulin
Species reactivity :
Human
Applications :
WB,IF-Cell,IHC-P,FC,IP
Conjugate :
Non-conjugated
Immunogen :
Recombinant protein within human beta 2 Microglobulin aa 1-119.
Uniprot id :
P61769>SwissProt: P61769 Human
Host :
Rabbit
Clone number :
PSH12-14
Isotype :
IgG
Size :
100μl
List Price :
649.00 USD
Storage Buffer :
PBS (pH7.4).
Form :
Liquid
Storage Instruction :
Store at +4℃ after thawing. Aliquot store at -20℃. Avoid repeated freeze / thaw cycles.
Purity :
Protein A affinity purified.
Product type :
Recombinant Rabbit monoclonal Antibody
Positive control :
HeLa cell lysate, Raji cell lysate, U-937 cell lysate, human lymph node tissue, human kidney tissue, HeLa.
Molecular wt :
Predicted band size: 14 kDa
Subcellular location :
Secreted, Cell surface.
Concentration :
1 mg/mL.
Recommended dilutions :
WB: 1:2,000
;IF-Cell: 1:1,000
;IHC-P: 1:1,000
;FC: 1:1,000
;IP: 1-2μg/sample
Advanced Validation :
Relative expression (RE)
Pic img4 :
https://storage.huabio.cn/huabio/productImg/HA751443_4.jpg
Pic legend4 :
Immunocytochemistry analysis of HeLa (positive) and SH-SY5Y (negative) labeling beta 2 Microglobulin with Rabbit anti-beta 2 Microglobulin antibody (HA751443) at 1/1,000 dilution.
Cells were fixed in 4% paraformaldehyde for 15 minutes at room temperature, permeabilized with 0.1% Triton X-100 in PBS for 15 minutes at room temperature, then blocked with 1% BSA in 10% negative goat serum for 1 hour at room temperature. Cells were then incubated with Rabbit anti-beta 2 Microglobulin antibody (HA751443) at 1/1,000 dilution in 1% BSA in PBST overnight at 4 ℃. Goat Anti-Rabbit IgG H&L (iFluor™ 488, HA1121) was used as the secondary antibody at 1/1,000 dilution. PBS instead of the primary antibody was used as the secondary antibody only control. Nuclear DNA was labelled in blue with DAPI.
Beta tubulin (HA601187, red) was stained at 1/100 dilution overnight at +4℃. Goat Anti-Mouse IgG H&L (iFluor™ 594, HA1126) was used as the secondary antibody at 1/1,000 dilution.
Pic img5 :
https://storage.huabio.cn/huabio/productImg/HA751443_5.jpg
Pic legend5 :
Flow cytometric analysis of SH-SY5Y (left, negative) and HeLa (right, positive) cells labeling beta 2 Microglobulin.
Cells were washed twice with cold PBS and resuspend. Then stained with the primary antibody (HA751443, 1/1,000) (red) compared with Rabbit IgG Isotype Control (green). After incubation of the primary antibody at +4℃ for an hour, the cells were stained with a iFluor™ 488 conjugate-Goat anti-Rabbit IgG Secondary antibody (HA1121) at 1/1,000 dilution for 30 minutes at +4℃. Unlabelled sample was used as a control (cells without incubation with primary antibody; black).
Pic img6 :
https://storage.huabio.cn/huabio/productImg/HA751443_6.jpg
Pic legend6 :
beta 2 Microglobulin was immunoprecipitated from 0.2 mg Raji cell lysate with HA751443 at 2 µg/10 µl beads. Western blot was performed from the immunoprecipitate using HA751443 at 1/2,000 dilution. HRP Conjugated Anti-Rabbit IgG for IP Nano-secondary antibody at 1/5,000 dilution was used for 1 hour at room temperature.
Lane 1: Raji cell lysate (input)
Lane 2: HA751443 IP in Raji cell lysate
Lane 3: Rabbit IgG instead of HA751443 in Raji cell lysate
Blocking/Dilution buffer: 5% NFDM/TBST
Exposure time: 3 minutes; ECL: K1802
more info or order :
company information

HUABIO
Founded in 2007, HUABIO is dedicated to developing high-quality antibodies that advance innovation. We are passionate about the accuracy, efficiency, and consistency of our products. That is why we have invested in new production platforms, like recombinant rabbit monoclonals, alpaca nanobodies, and adopted aggressive QA standards to deliver cutting-edge antibodies with uncompromised quality.
We hope to see you at your next discovery!
We hope to see you at your next discovery!
related products
browse more products
questions and comments
